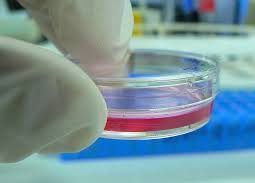
Differences Between Primary Cell Culture and Subculture
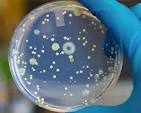
Purification Methods for Contaminated Microbial Strains

Principle and Influencing Factors of Moist Heat Sterilization
News 8 5 月, 2025
Principle of Moist Heat Sterilization: Moist heat sterilization works by causing denaturation of proteins and nucleic acids in microorganisms, leading to their death. This denaturation begins with the breaking of hydrogen bonds, which disrupts the internal structure of proteins and nucleic acids, rendering them non-functional. Moist heat sterilizatio…
Causes of Cytoplasmic Vacuoles in Cell Culture and Solutions
News 8 5 月, 2025
Many researchers encounter cytoplasmic vacuolization during cell culture. But what causes vacuoles to form in cells, and how can we prevent it? What Are Cytoplasmic Vacuoles? Cytoplasmic vacuoles are bubble-like structures visible under a light microscope, showing optical differences from the cytoplasm. The process of vacuole formation is called …
Differences Between Primary Cell Culture and Subculture
News 8 5 月, 2025
1. Different Definitions Primary culture refers to directly obtaining tissue or organ samples from an organism and culturing them; it’s also called initial culture. The culture is maintained outside the organism without splitting or transferring during the process. Subculture (passage culture) involves splitting cultured cells into smaller portions …
Phenol Red Indicator in Cell Culture
News 8 5 月, 2025
Why is phenol red added to cell culture media? When should phenol red–free media be used? Phenol red is a common pH indicator. It’s typically added to culture media to help monitor pH levels and observe cell growth. In media containing phenol red: At pH ≤ 6.8, the medium appears yellow. As pH increases toward 7.4, the medium turns red. At p…
Purification Methods for Contaminated Microbial Strains
News 8 5 月, 2025
During the isolation, preservation, and production of microbial strains, contamination with unwanted microorganisms is common. Therefore, purifying contaminated strains is essential before they can be used in production. Depending on the type and severity of contamination, different purification methods are employed. 1. Removing Bacterial or Yeast Conta…
The Role of Bile Salts in Microbial Culture Media
News 8 5 月, 2025
In microbiology, especially when cultivating intestinal pathogenic bacteria, many culture media include an ingredient called bile salts. But how exactly are bile salts used in microbial culture, and what is their role? Bile salts refer to the sodium or potassium salts of bile acids. Bile acids are secondary bile acids (derived from primary bile acids) c…
Understanding Color Changes in Cell Culture Media
News 24 4 月, 2025
During cell culture, changes in media color often reflect the condition of the cells. Typically, media appears red due to its pH (~7.4) and the presence of phenol red. However, the exact color can vary depending on the media type. For instance, DMEM tends to appear darker than RPMI-1640 because it contains more phenol red. Some media are colorless or pale …
Primary Cell Culture Tips and Techniques
News 24 4 月, 2025
Primary cells are initial cells obtained from living tissues through specific isolation methods. These cells are freshly isolated, not immortalized, and retain most of their original genetic and physiological traits. This makes them highly valuable for experiments requiring physiological relevance, such as drug testing, cell differentiation, and transforma…
Why Do Some Positive Blood Cultures Fail to Grow Bacteria?
News 24 4 月, 2025
A positive blood culture result with no bacterial growth has long puzzled clinical microbiologists. Distinguishing a false positive from other causes of culture failure can be challenging. Here, we summarize and analyze the common causes of false positives and culture failures in blood culture to aid in judgment. Environmental Factors Drastic Te…
When to Use Culture Flasks vs. Multi-Well Plates for Cell Culture
News 24 4 月, 2025
In vitro cell culture requires cells to adhere to artificial surfaces. Most vertebrate cells grow in a monolayer on these surfaces, typically culture flasks, dishes, or multi-well plates. Basic Concepts Based on material, culture surfaces are usually disposable plastic or glass. Glass is low-cost and reusable with good light transmission but has beco…
The Role of Glutamine in Cell Culture
News 8 4 月, 2025
L-glutamine, an amino acid encoded in protein synthesis, is a common supplement in serum-free media, used to support the proliferation and maintain the physiological functions of various mammalian cells. In common cell culture media, the concentration of glutamine varies from 0.5 mM in Ames’ medium to 10 mM in MCDB 131 medium, typically within the ra…
Influencing Factors of Plant Cell Suspension Culture
News 8 4 月, 2025
Plant cell suspension culture is a common cell culture technique widely used for producing secondary metabolites, such as polysaccharides, saponins, alkaloids, flavonoids, and polyphenols. What is Cell Suspension Culture? Plant cell suspension culture refers to the cultivation of plant cells or small cell clusters in a liquid medium on a shaker. Thes…